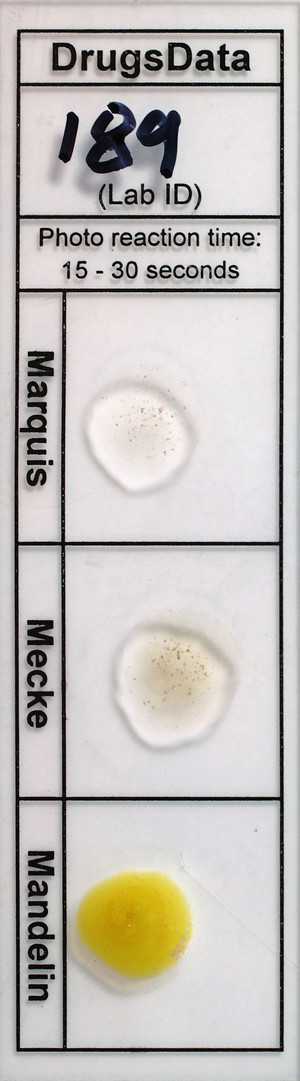
Detail Photo

New Submissions Are Not Currently Being Accepted
Samples sent after April 10, 2024 will be put on hold.
Viewing desktop version: Switch to Mobile
White Powder
Sold as: Not Specified
ID: 13773
Sold as: Not Specified
Expected to be: Not Specified
Has Been Tried: Yes
Description
White powder from a round white round tablet with K 18 marking and break line. [DrugsData accepts partial tablets and pulverized tablets by prior approval only.]